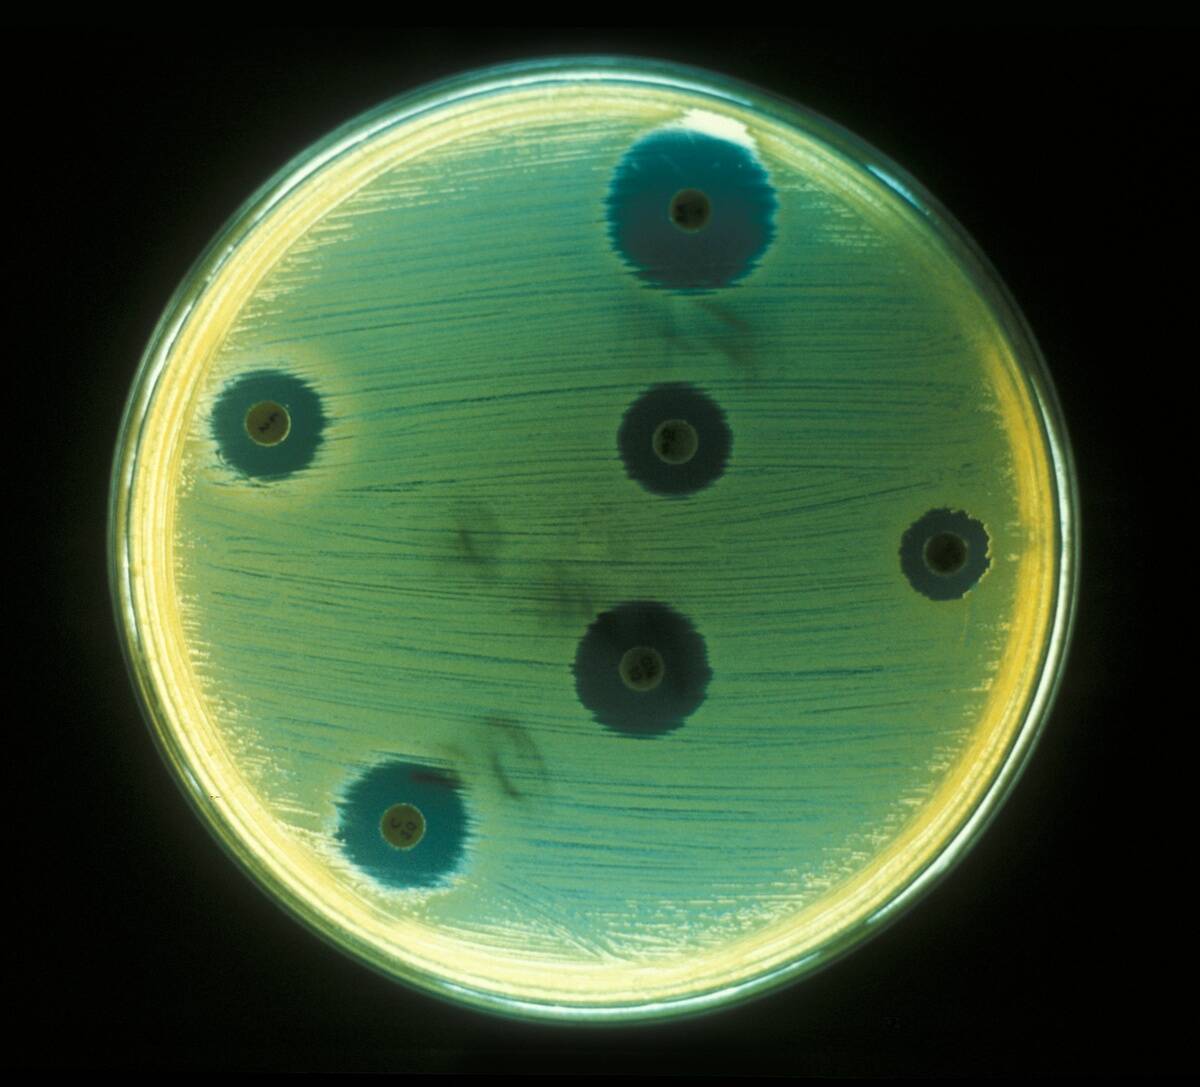
Staphylococcus Aureus

How life thrives below the Earth’s surface
Trending Now
Grab a helmet lamp—this is a 20-stop tour of the deep, where ecosystems hum along without a single sunbeam. Beneath our feet, water-filled cracks, porous rocks, and cavern pools host organisms that power themselves with chemistry. Think of it as Earth’s backstage: quiet, pressurized, mineral-rich, and surprisingly lively. From microbes sipping hydrogen to blind salamanders feeling their way through karst, it’s a who-knew kind of biodiversity.
Unlike flashy coral reefs, the subsurface runs on slim energy budgets and patience. Food webs start with microbes that fix carbon using electron donors like hydrogen, sulfide, or ferrous iron. These tiny chemists feed grazers, which feed predators, building communities in spaces a paperclip could barely squeeze through. The living room? Anything from a dripping cave ceiling to fractures kilometers down in the continental crust or beneath the seafloor.
How deep does life go? From cave pools to kilometers of crust

Life reaches astonishing depths. In South Africa’s gold mines, active bacteria and even nematodes have been found between roughly 0.9 and 3.6 kilometers underground. Microbial communities also occur hundreds to thousands of meters beneath the seafloor in sediments and basaltic crust recovered by ocean drilling. While the Kola Superdeep Borehole plumbed to 12.26 kilometers, temperatures and dryness there limit biology; still, multiple sites show that microbes push several kilometers into the crust where water, pore space, and chemistry align.
Depth often means heat and pressure. Rock temperatures can climb tens of degrees per kilometer, and pressures reach tens to hundreds of megapascals. Yet cells persist in fracture waters and tiny pores where nutrients trickle in. Even multicellular life gets in on it: a deep-living nematode, informally dubbed the devil worm, was recovered from South African mine water more than a kilometer down. It’s a reminder that biology exploits any habitable nook it can find.
Sunlight optional: chemosynthesis powers hidden food webs

No sun? No problem. Chemosynthetic microbes build organic matter by oxidizing electron donors like hydrogen, sulfide, methane, or ferrous iron and reducing acceptors such as oxygen, nitrate, or sulfate. In sulfidic caves, mats of sulfur-oxidizing bacteria form stringy veils that look like angel hair, fixing carbon that fuels amphipods, snails, and specialized insects. In marine sediments, methane-oxidizing consortia at the sulfate–methane transition knit carbon into biomass that higher organisms can ultimately tap.
These systems aren’t speedy. Energy yields are modest compared with photosynthesis, so biomass accumulates slowly and turnover is glacial. Still, chemosynthesis stitches together entire food webs. Stable isotope signatures in cave and subsurface animals often trace back to chemolithoautotrophic carbon, confirming that primary production can be completely decoupled from sunlight. If you’ve ever seen pale films or drippy snot-like colonies in caves or vents, you’ve glimpsed the power plant at work.
Rock-eating microbes: lithoautotrophs that dine on minerals

Lithoautotrophs harvest electrons directly from reduced minerals and gases. Groundwater iron-oxidizers such as Gallionella and Leptothrix build twisted stalks and sheaths as they turn ferrous iron into ferric oxyhydroxides. Acidithiobacillus ferrooxidans feeds on sulfide and iron in metal-rich rocks, a process that can leach metals but also mobilize acidity. In basaltic aquifers, microbes tap Fe(II) in volcanic glass; microscopic tubular etchings in oceanic basalts are consistent with bioalteration by mineral-eating communities.
These metabolisms fix CO2 using pathways like the Calvin cycle or the Wood–Ljungdahl pathway, turning geochemistry into dinner. Geobacter and relatives go the other way, reducing insoluble iron oxides and even producing tiny currents to shunt electrons outside the cell. Whether oxidizing or reducing, the result is a feedback loop between rock and life: minerals weather faster, redox gradients sharpen, and new niches appear for the next microbial pioneer.
Nature’s nuclear snack bar: radiolysis making hydrogen underground

Deep in ancient crystalline rocks, natural radioactivity splits water molecules in a process called radiolysis. Decay of uranium, thorium, and potassium liberates hydrogen gas and oxidants like hydrogen peroxide. In sealed fractures, that hydrogen can accumulate to levels high enough to feed hydrogenotrophic microbes for geologic timescales. At Canada’s Kidd Creek mine and South Africa’s Witwatersrand Basin, fracture waters rich in hydrogen and sulfate sustain independent food webs with no links to the photosynthetic surface.
These waters can be incredibly old. Isotopic and noble gas analyses indicate some Canadian Shield fluids have been isolated for millions to over a billion years. Yet they remain chemically energetic because radiolysis never really stops. Microbes pair radiolytic hydrogen with electron acceptors from the rock—sulfate produced when radiolytic oxidants attack sulfide minerals—to drive metabolisms like sulfate reduction and methanogenesis. It’s a natural trickle charger for life in the dark.
Geology as a generator: serpentinization and other H2 factories

When ultramafic rocks like olivine meet water, they transform into serpentine and magnetite, releasing hydrogen in the process—serpentinization. The Lost City hydrothermal field on the Mid-Atlantic Ridge is a showcase: towering carbonate chimneys vent 40–90°C, pH 9–11 fluids loaded with hydrogen and methane, nurturing dense biofilms of methanogens and sulfate reducers. On land, springs at places like The Cedars in California and the Samail Ophiolite in Oman similarly exhale alkaline, hydrogen-rich waters.
Other geologic processes pitch in. Water-rock reactions in basaltic crust, radiolysis, and even mechanical crushing of rocks during earthquakes can generate pulses of hydrogen. These H2 factories feed subsurface chemosynthesis, bootstrapping ecosystems in settings far from sunlight. The details vary—temperature, pH, trace metals—but the theme is the same: geology writes the energy script, and microbes read it flawlessly, converting redox currency into cells, exopolymers, and eventually food for grazers.
The celebrity of the deep: Candidatus Desulforudis audaxviator’s solo act

Meet a one-microbe ecosystem. Candidatus Desulforudis audaxviator was discovered in 2.8-kilometer-deep fracture water in South Africa’s Witwatersrand Basin. The water was around 60°C, anoxic, and rich in radiolytic hydrogen and sulfate from mineral reactions. Genomic analysis revealed that this bacterium carries genes to fix carbon, fix nitrogen, and reduce sulfate—essentially running its own closed-loop food web with minimal help from anyone else.
Its name nods to Jules Verne’s audax viator, daring traveler, and it earns the title. Without sunlit organics, it uses the Wood–Ljungdahl pathway to fix CO2 and couples it to sulfate reduction for energy. It even has DNA repair and stress-response systems tailored to the deep’s slow-motion life. While no microbe is an island forever, Ca. D. audaxviator comes impressively close, making it a poster child for life independent of the surface.
Life in slow motion: microbes with century-long doubling times
Underground life runs on a very slow clock. Energy trickles in so sparsely that estimated generation times for deep subsurface microbes can stretch from years to centuries. In marine sediments miles below the sea surface, cell turnover is often measured in hundreds to thousands of years. That means communities can persist with astonishing stability, riding out climate swings and sea-level changes while barely dividing.
Yet slow isn’t stagnant. Experiments have coaxed aerobic bacteria from South Pacific abyssal clays—sediments up to 101.5 million years old—back into growth when supplied with oxygen and nutrients, though enrichment took months. In situ, however, most cells invest in maintenance and repair rather than reproduction. DNA repair enzymes, streamlined metabolisms, and efficient scavenging systems are the evolutionary toolkit for passing time when your next meal might arrive on a geologic schedule.
Big invisible biomass: the deep biosphere’s carbon by the petagram

It’s out of sight but not out of scale. The Deep Carbon Observatory estimated that the deep biosphere holds roughly 15 to 23 petagrams of carbon—comparable to or exceeding the biomass of all humans, which sits near 0.06 petagrams. By cell counts, that’s on the order of 2 to 6 × 10^29 microbial cells spread through sediments, crust, and continental rocks. Many are dormant or slow-growing, but collectively they represent a major planetary compartment.
This biomass is patchy: dense near energy-rich interfaces like sulfate–methane transitions, sparse in nutrient-poor clays. Still, the numbers add up across vast volumes of rock and sediment. Because it turns over so slowly, the deep biosphere can act as a long-term carbon reservoir. And when conditions change—say, a fracture opens or fluids mix—these communities can awaken, rerouting local chemistry in ways that ripple through groundwater or seafloor ecosystems.
Cave creatures with makeovers: blind fish, pallid bugs, and troglomorphy

Troglomorphy is the makeover kit for cave life: reduced or absent eyes, loss of pigment, elongated limbs and antennae, and extra sensory hairs. The Mexican blind cavefish Astyanax mexicanus famously evolves eye loss and pigmentation changes in multiple cave populations, making it a model for studying development and genetics. The olm, Proteus anguinus, a pale, eel-like salamander from European karst, can live for decades in darkness and survive long periods with little to no food.
Invertebrates go all-in too.
Cave beetles, isopods, and amphipods often become ghostly white and hyper-sensitive to vibrations and chemical cues. With photosynthetic inputs scarce, many cave food webs depend on drip-delivered organics, bat guano, or chemosynthetic mats where sulfide-rich waters seep in. The result is a menagerie that’s both minimalist and highly specialized—proof that evolution happily trades eyesight for touch and smell when the lights go out for good.
Sulfurous sanctuaries: Movile Cave and other sulfidic systems

Romania’s Movile Cave, discovered in 1986 near Mangalia, is a textbook chemosynthetic sanctuary. Its atmosphere is low in oxygen (roughly 7–10% versus the usual 21%) and enriched in carbon dioxide and hydrogen sulfide. Microbial mats of sulfur-oxidizing bacteria coat the water surfaces and walls, fixing carbon that supports a food web of endemic invertebrates—dozens of species found nowhere else. The cave has been physically isolated for long periods, allowing this sulfur-driven ecosystem to run largely on its own.
Elsewhere, Italy’s Frasassi caves and Mexico’s Cueva de Villa Luz host dripping, acidic “snottites” formed by sulfur-oxidizing microbes, often dominated by Acidithiobacillus species. These gooey colonies can reach pH near 0, etching limestone and creating otherworldly textures. As sulfide-rich waters mix with oxygen, steep redox gradients bloom—perfect for chemosynthesis. Visitors smell the chemistry before they see it; that rotten-egg tang is the signal that sulfur cycling is in full swing.
Beneath the seafloor: microbes thriving under ocean sediments

Globally, marine sediments blanket the seafloor and house microbial communities from the surface down hundreds to thousands of meters. Cell densities typically fall from millions per cubic centimeter near the seabed to just hundreds or fewer in deeper layers. International Ocean Discovery Program (IODP) cores show life threaded through clays, sands, and basaltic crustal aquifers. Temperatures increase with depth, and active life has been documented near the upper thermal limits tolerated by microbes in ridge-flank systems.
Subseafloor metabolisms include sulfate reduction, methanogenesis, and anaerobic oxidation of methane (AOM), especially where upward-diffusing methane meets downward-penetrating sulfate. At these sulfate–methane transition zones, consortia of archaea and bacteria knit delicate biofilms and precipitate carbonates. Farther below, microbial communities occupy the cracks and pores of oceanic basalts, drawing on fluids that circulate through the crust. It’s a slow, chemical dance that quietly processes carbon and sulfur on a planetary scale.
Hidden rivers: aquifers, stygobionts, and groundwater food chains

Groundwater is Earth’s hidden ocean, storing the vast majority of the planet’s liquid freshwater outside ice. Flowing through pores and fractures, it moves from meters to kilometers per day in karst conduits, far slower in tight sediments. In these dark rivers, stygobionts—obligate groundwater organisms like amphipods and blind salamanders—graze on biofilms, detritus washed in from the surface, or, in special cases, chemosynthetic carbon where reduced waters emerge.
Food chains depend on geology. Limestone karst often imports leaf litter and soil microbes, while sulfidic aquifers grow sulfur-oxidizing mats. Redox gradients govern water quality, too: iron- and manganese-oxidizing bacteria can foul wells with rust-colored deposits, while sulfate reducers generate sulfide that can corrode infrastructure. Managing aquifers means minding biology as much as hydrology, because those biofilms and microbial reactions quietly set the chemistry that people pump to the surface.
Lava tubes and basalt bunkers: volcanic real estate for life

Volcanic rocks make excellent hideouts. Lava tubes in places like Hawaii and Iceland shelter communities from temperature swings, desiccation, and radiation. White, fuzzy microbial colonies and mineral crusts line walls and ceilings, with DNA surveys often turning up Actinobacteria and other rock-associated taxa. In oceanic crust, thin sections of basaltic glass reveal tubular micro-etchings observed in basaltic glass that are interpreted by many researchers as evidence of microbial bioalteration.
These habitats are astrobiology darlings. Serpentinization and basalt alteration can generate hydrogen and organics, while the tubes provide stable microclimates. If life ever took hold on Mars, lava tubes there would be prime refuges against surface radiation and dryness—mirroring how Earth’s microbes use volcanic real estate. Back home, fluids percolating through basalts carry nutrients and electron donors, supporting biofilms that can influence everything from mineral weathering to groundwater chemistry.
Breathing rocks: iron, manganese, and sulfur as electron acceptors

When oxygen is scarce, microbes turn to rocks and dissolved ions as electron sinks. Geobacter and Shewanella reduce ferric iron and manganese oxides, often producing magnetite and dissolving metal oxides in the process. Some strains even export electrons along conductive pili or to minerals outside the cell, effectively running tiny external circuits. In many aquifers and sediments, denitrification and manganese reduction kick in after oxygen is depleted, followed by iron and sulfate reduction deeper down.
Sulfate reducers like Desulfovibrio pair organic compounds or hydrogen with sulfate, generating sulfide that reacts with metals to form minerals such as pyrite. These stacked redox processes create natural zonation in sediments and rocks—layers where different microbes dominate based on the available electron acceptors. The outcome isn’t just academic: it affects the mobility of contaminants and nutrients, cementing grains here and dissolving them there, and ultimately sculpting the subsurface’s chemical architecture.
Viral string-pullers: phages steering genes and community dynamics

Viruses don’t vanish underground; they recalibrate the rules. In soils and marine sediments, viral particles can reach millions to billions per gram near the surface and persist, at lower numbers, at depth. By infecting key chemoautotrophs and heterotrophs, phages redirect carbon flow—killing cells and releasing dissolved organic matter in a classic viral shunt. Metagenomes from subsurface habitats are rich in CRISPR spacers, evidence of long-running host–virus arms races.
Some phages carry auxiliary metabolic genes that tweak host pathways during infection, including genes tied to sulfur and nitrogen cycling. That means a virus can briefly upgrade a host’s metabolism to maximize viral replication, with community-wide ripple effects. In energy-limited settings, these dynamics can set the pace of turnover and gene exchange, seeding new traits through horizontal transfer. Even in the deep, evolution doesn’t nap—it rides on capsids as much as on cell division.
Ancient time capsules: brines, salts, and permafrost harboring survivors

Some subsurface waters are old enough to remember supercontinents. In Canada’s Precambrian Shield, fracture brines isolated for millions to over a billion years carry hydrogen, helium, and sulfate signatures of long confinement and radiolysis. Microbes inhabit these pockets, adapted to high salinity and limited nutrients. In salt deposits, halophilic archaea and bacteria have been revived from fluid inclusions in halite thousands of years old, and ancient DNA persists even longer within crystals.
Permafrost adds a cryogenic twist. Viable bacteria and viruses have been recovered from Siberian permafrost tens of thousands of years old, including giant viruses like Pithovirus and Mollivirus revived after roughly 30,000 years. Nematodes have also been reanimated from Late Pleistocene sediments. While claims of far older revivals remain debated, the takeaway is clear: cold, salty, and sealed environments can preserve life astonishingly well, offering windows into ancient ecosystems and adaptation.
Extreme conditions 101: heat, pressure, darkness, and low oxygen

The deep checklist isn’t gentle: high temperature, crushing pressure, perpetual night, and often little to no oxygen. Many subsurface microbes tolerate pressures of tens to over a hundred megapascals and temperatures approaching known upper limits for life near 122°C in lab-grown hyperthermophiles. In alkaline serpentinizing systems, pH soars above 10; in sulfuric caves, microbial films can sit in acids near pH 0. Brines test salinity tolerance, while tight rocks challenge cells to move and communicate through micrometer pores.
Survival strategies are equally rugged. Membranes and proteins tuned for pressure and heat, enzymes that repair DNA and proteins, and energy-efficient metabolisms dominate. Cells hunker down in biofilms and mineral crevices, where gradients and trace nutrients concentrate. Darkness removes photosynthesis, but it also slows harmful reactions. The result is a biosphere built for endurance, not speed—biochemistry pared to essentials, optimized for decades-to-centuries between jackpots of usable energy.
How scientists peek below: boreholes, mines, clean labs, and DNA clues

Getting honest samples from the deep is half the battle. Scientists tap mines like Mponeng and Kidd Creek, drill boreholes on land, and core the seafloor with IODP expeditions. Downhole observatories called CORKs seal into boreholes to track pressure, temperature, and fluids over years, while tracer dyes and tiny fluorescent beads flag contamination. Samples ride up to clean labs where sterile workflows and perfluorocarbon tracers help separate true residents from hitchhikers.
Once in the lab, the toolkit blossoms: microscopy and FISH to spot cells, cultivation for the lucky few, and culture-independent methods for the rest. 16S rRNA surveys map who’s there; metagenomics and single-cell genomics reveal metabolic blueprints; metatranscriptomics and proteomics catch cells in the act. Stable isotope probing ties metabolisms to specific taxa, and geochemical measurements close the loop. Piece by piece, these lines of evidence sketch life’s shadowy underground cityscape.